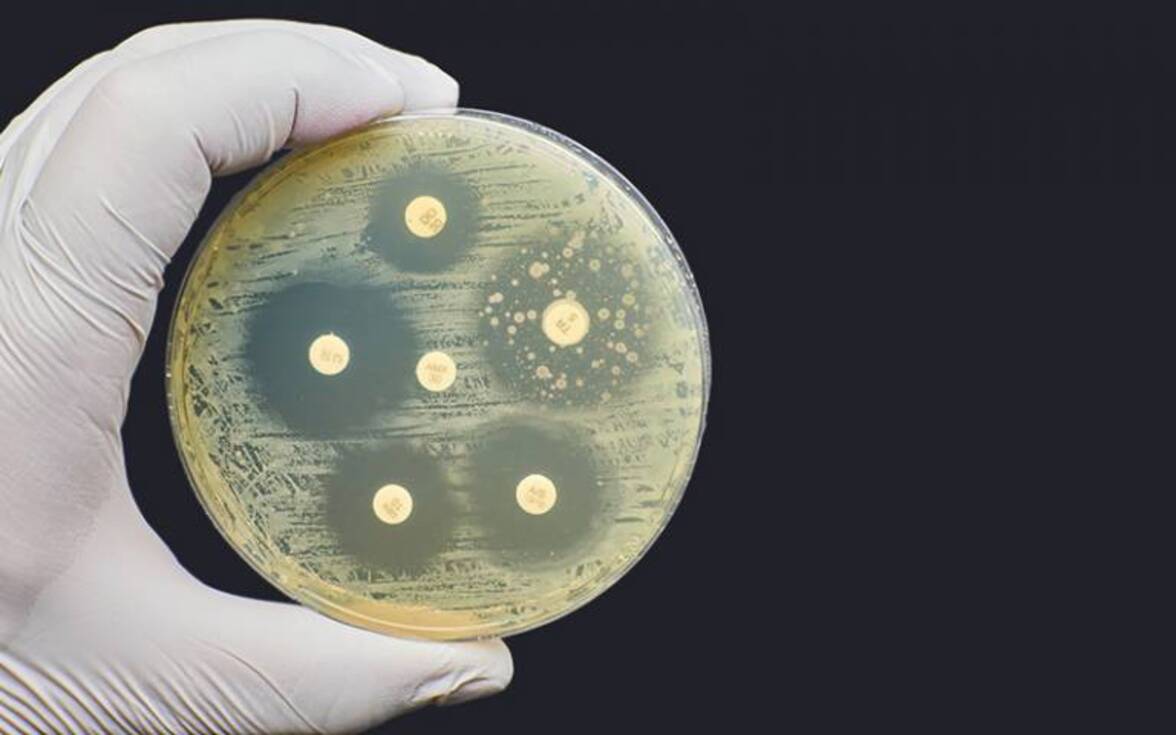
Эволюция резистентности к антибиотикам ассоциируется с коллатеральными лекарственными фенотипами у Mycobacterium tuberculosis

Инфекции, вызванные Mycobacterium tuberculosis, остаются глобальной проблемой здравоохранения.
Полностью чувствительные к лекарствам штаммы M. tuberculosis можно лечить комбинацией из четырех препаратов в течение шести месяцев, что при правильном приеме позволяет добиться излечения примерно в 85% случаев. Однако несоблюдение пациентом режима лечения и неоптимальное проникновение лекарств часто приводят к неудаче лечения, что способствует развитию и распространению лекарственной резистентности у M. tuberculosis ко всем клинически используемым антибиотикам.
Даже в отношении недавно одобренных препаратов бедаквилина и претоманида уже наблюдается клиническая устойчивость, даже в популяциях, не получавших лечения. Лекарственно-устойчивые штаммы M. tuberculosis трудно поддаются терапии, требуя более длительных схем лечения, а также имеют более токсичные побочные эффекты. Это подчеркивает необходимость не только в новых препаратах, но и в рациональных подходах к разработке комбинированных методов лечения, позволяющих сократить продолжительность лечения и предотвратить возникновение лекарственной резистентности.
Исследования на различных видах бактерий и линиях раковых клеток показали, что эволюция лекарственной резистентности может иметь побочные лекарственные фенотипы, которые изменяют чувствительность (т.е. либо сенсибилизацию, либо резистентность) к другим функционально или структурно не связанным препаратам. Хотя существуют различия в:
(i) воспроизводимости эволюционных путей, приводящих к появлению сопутствующих фенотипов,
(ii) влиянии различных генотипов в рамках одного гена и
(iii) коллатеральных взаимосвязей между различными видами,
использование сопутствующих лекарственных фенотипов открывает большие терапевтические перспективы. Например, комбинации препаратов с перекрывающимися коллатеральными чувствительностями могут быть использованы для отбора против возникновения лекарственной резистентности, а препараты, направленные на коллатеральные фенотипы и обладающие повышенной эффективностью против резистентных вариантов, могут быть использованы для быстрого устранения резистентных вариантов и сокращения времени лечения. В качестве альтернативы, выявление сопутствующей (коллатеральной) резистентности позволит определить комбинации препаратов, которых следует избегать.
Есть основания предполагать, что у микобактерий существуют коллатеральные лекарственные фенотипы. У M. tuberculosis штаммы с множественной лекарственной резистентностью обладают повышенной чувствительностью к β-лактамам , а мутации в транскрипционном регуляторе rv0678 приводят к перекрестной резистентности между бедаквилином и клофазимином.
У Mycobacterium smegmatis резистентность низкого уровня к фторхинолонам приводит к резистентности к ряду препаратов для лечения туберкулеза, включая изониазид и этионамид. Хотя многие малые молекулы были протестированы на активность против лекарственно-устойчивых клинических изолятов M. tuberculosis, выводы о сопутствующих лекарственных фенотипах осложняются отсутствием изогенного чувствительного к лекарствам родительского штамма, с которым можно было бы адекватно сравнить изменения в чувствительности.
В данном исследовании мы попытались устранить этот пробел в знаниях путем выявления сопутствующих эффектов лекарственной резистентности у M. tuberculosis. Чтобы преодолеть отсутствие изогенного эталонного штамма, мы вырастили резистентные штаммы M. tuberculosis против панели из 23 клинически значимых препаратов с различными структурами и механизмами действия.
Были определены профили чувствительности резистентных мутантов и установлены взаимосвязи между генотипом и фенотипом. Были выявлены примеры сопутствующей лекарственной сенсибилизации, причем большинство сопутствующих лекарственных сенсибилизаций были однонаправленными и в некоторых случаях сохранялись среди генетически различных резистентных фонов. Мы также выявили примеры перекрестной резистентности и еще больше расширили фармакофоры, подверженные эффлюксу за счет мутаций в rv0678. Наконец, комбинации антибиотиков с перекрывающимися сопутствующими фенотипами были способны селективно устранять резистентные штаммы из смешанной популяции и могли отсрочить, а в некоторых случаях и предотвратить возникновение лекарственной резистентности.
Эти результаты подчеркивают терапевтический потенциал использования сопутствующих фенотипов лекарств для разработки новых схем лечения M. tuberculosis. Данная работа в сочетании с вкладом других авторов подчеркивает, как улучшенное понимание биологии и последствий лекарственной резистентности может определить уникальные терапевтические стратегии для революционного изменения борьбы с антимикробной резистентностью.